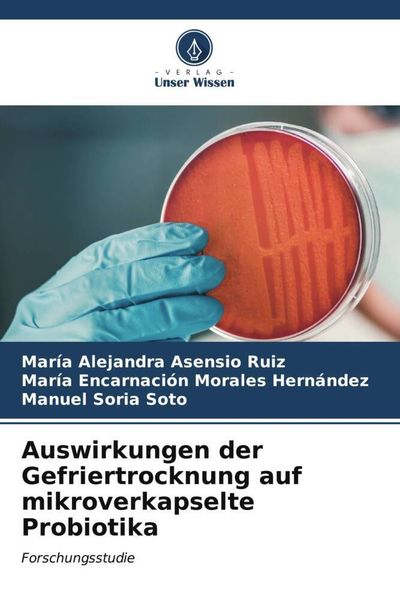

Ergebnisse für "probiotika"

Probiotics Gas & Bloating (120 Kapseln) Nahrungsergänzungsmittel, Probiotika, Verdauung, Magen, Darm, Verdauungsgesundheit, Blähungen, Darmgesund...
€49.99
inkl. MwSt. zzgl. Versand
Versand: €0.00

Dr.OHHIRA Deluxe Probiotika, Postbiotisch, Präbiotisch -Für darmsanierung- Darmkur, Darmbakterien-12 Stämme, 5 Jahre Fermentation, 100 Milliard...
€38.00
inkl. MwSt. zzgl. Versand
Versand: €0.00

Omniflora N Probiotika Kapseln für die Darmflora 20 St
€12.01(€600.50 / ct)
inkl. MwSt. zzgl. Versand
Versand: €3.99

Mikrobielle Verbündete: Probiotika Bei Der Behandlung Von Parodontalerkrankungen, Taschenbuch von Priya Tomar , Gunjan Gupta , Sakshi Manhas, Verlag
€43.90
inkl. MwSt. zzgl. Versand
Versand: €0.00

Provicell EM Vital 250 ml | Probiotika Katze | Natürliche Darmsanierung für Katzen | Mit Tierärzten entwickelt | Fördert die Verdauung I BARF-Z...
€14.95
inkl. MwSt. zzgl. Versand
Versand: €5.50

Auswirkungen der Gefriertrocknung auf mikroverkapselte Probiotika
€59.90
inkl. MwSt. zzgl. Versand
Versand: €0.00

Probiotika 10 Milliarden KTJ 60 Kapseln
€8.11
inkl. MwSt. zzgl. Versand
Versand: €6.00

Nordics Natürliche Kinderzahnpasta mit Erdbeergeschmack und Probiotika 50 ml
€3.79
inkl. MwSt. zzgl. Versand
Versand: €4.99

Pedigree Hundesnacks Multivitamins Verdauung - 30 weiche Hundeleckerlis mit Probiotika, 6x180g - Supplements zur Unterstützung der Verdauung, einf...
€35.65
inkl. MwSt. zzgl. Versand
Versand: €0.00

AlzaEco Sensitive Waschgel mit Probiotika 3 l (60 Wäschen)
€31.09
inkl. MwSt. zzgl. Versand
Versand: €0.00

Probiotika in Brackwasser, Taschenbuch von Datta Ashok Nalle, Verlag Unser Wissen, 9786204572857
€43.90
inkl. MwSt. zzgl. Versand
Versand: €0.00

Wirkung von Chitin und Probiotika auf Cholesterin im Blut und Eigelb, Taschenbuch von Ezhil Valavan Subbiah , Edwin S. C. , Amutha Ramasamy, Verlag
€54.90
inkl. MwSt. zzgl. Versand
Versand: €0.00

Shampoo mit Apfelessig und Probiotika 5 Probiotika (Apfelessig-Shampoo) - Volumen: 300 ml
€17.76
inkl. MwSt. zzgl. Versand
Versand: €0.00

Waffel Mit Milch Und Kakao-Creme Mit Probiotika
€1.99
inkl. MwSt. zzgl. Versand
Versand: €6.99

AlzaEco Universal-Waschgel mit Probiotika 3 l (60 Wäschen)
€30.35
inkl. MwSt. zzgl. Versand
Versand: €0.00

Einfluss des Kalziumkations auf die Mikroverkapselung von Probiotika, Taschenbuch von María Alejandra Asensio Ruiz , María Encarnación Morales
€45.90
inkl. MwSt. zzgl. Versand
Versand: €0.00

ESN Biotic Pro, 30 Probiotika Kapseln für Darmflora, 4 klinisch studierte Bakterienstämme
€48.99
inkl. MwSt. zzgl. Versand
Versand: €0.00

Probiotika für Hunde – 500g Premium-Leckerli für gesunde Verdauung, starke Abwehr & rundum Wohlbefinden
€34.99
inkl. MwSt. zzgl. Versand
Versand: €0.00

MOLIV Feuchtigkeitscreme mit lebenden Probiotika 30ml
€39.00
inkl. MwSt. zzgl. Versand
Versand: €0.00

Probiotika - ein Überblick, Taschenbuch von Sri Krishna Chaitanya Putta , G. Santhi , Bontu Sravani, Verlag Unser Wissen, 9786204543222
€39.90
inkl. MwSt. zzgl. Versand
Versand: €0.00

Sante Conditioner Sensitiv Care 150ml Probiotika + 3-Fach Protein Komplex - Sanft & Schützend - sensible Kopfhaut
€4.14(€27.60 / l)
inkl. MwSt. zzgl. Versand
Versand: €4.90

Apis Synbiotic Tagescreme mit Probiotika und Präbiotika
€12.98
inkl. MwSt. zzgl. Versand
Versand: €4.95

Bewertung der antibakteriellen Eigenschaften von kommerziellen Probiotika, Taschenbuch von Shruti Rajwar , Varsha Singh, Verlag Unser Wissen,
€39.90
inkl. MwSt. zzgl. Versand
Versand: €0.00

DERBY Darm-Support mit Probiotika 3 kg Eimer
€32.99(€10,996.67 / kg)
inkl. MwSt. zzgl. Versand
Versand: €0.00

Probiotika das Wundernahrungsmittel, Taschenbuch von Madhumita Sen, Verlag Unser Wissen, 9786204878850
€32.90
inkl. MwSt. zzgl. Versand
Versand: €0.00

Microflorana -F Direct 500 ml - Probiotika - Darmsanierung - Milchsäurebakterien - Vitamine & Mineralstoffe - Darmbakterien - Probiotika flüssig
€20.83
inkl. MwSt. zzgl. Versand
Versand: €4.99

PROTEGO Elektrolyte + Probiotika Salvum Lab 20 Brausetabletten
€3.09
inkl. MwSt. zzgl. Versand
Versand: €3.99

Mikrobiota und Typ-2-Diabetes: Die Rolle von Probiotika, Taschenbuch von Mohammed SOBH, Verlag Unser Wissen, 9786200760838
€43.90
inkl. MwSt. zzgl. Versand
Versand: €0.00

MOLIV Gesichtscreme mit lebenden Probiotika. Anti-Aging 30 ml
€39.00
inkl. MwSt. zzgl. Versand
Versand: €0.00

DARMFLORA PLUS | tägliche Verdauungsbalance | Probiotika & Präbiotika für Hunde
€24.90
inkl. MwSt. zzgl. Versand
Versand: €3.90

Die medizinische Bedeutung von Probiotika und HCV-Infektionen, Taschenbuch von Maii Moustafa Nabieh, Verlag Unser Wissen, 9786207793303
€44.90
inkl. MwSt. zzgl. Versand
Versand: €0.00

6x Bonomelli Tisane con Probiotico Dopo Pasto Kräutertees mit Probiotika mit Minz-, Eisenkraut- und Ingwerextrakt ideal nach den Mahlzeiten Packun...
€26.75
inkl. MwSt. zzgl. Versand
Versand: €0.00

PEAFEN PEA 350 mg – Mikronisiertes Palmitoylethanolamid, natürlich entzündungshemmend, mit Probiotika, Zink & Vitamin D3 – 60 Kapseln für...
€34.90
inkl. MwSt. zzgl. Versand
Versand: €0.00

Protexin -Kult Infantis Probiotika für Kinder mit 7 Stämmen lebender, freundlicher Bakterien, 8 Beutel
€17.95
inkl. MwSt. zzgl. Versand
Versand: €6.10

Probiotika, Taschenbuch von Akshatha Gadiyar , Anil Ankola, Verlag Unser Wissen, 9786206941545
€64.90
inkl. MwSt. zzgl. Versand
Versand: €0.00

Liposomale Probiotika Kulturen Komplex Tropfen hochdosiert - 35 Bakterienstämme mit Inulin und 100 Mrd. KBE pro Tagesdosis
€49.90
inkl. MwSt. zzgl. Versand
Versand: €0.00

Relief Sun: Reis + Probiotika SPF50+ Sonnencreme 50ml
€14.47
inkl. MwSt. zzgl. Versand
Versand: €0.00

Aavalabs Probiotika Kapseln mit Prebio-Inulin | 30 Stämme | 90 Kapseln
€29.99
inkl. MwSt. zzgl. Versand
Versand: €0.99

INTIMFLORA Probiotika Kapseln 60 St
€22.99(€383.17 / ct)
inkl. MwSt. zzgl. Versand
Versand: €0.00

Globale Bedeutung von Laktobazillen als Probiotika, Taschenbuch von Farhatul-Ain Arshad , Muhammad Annus Khan, Verlag Unser Wissen, 9786204551159
€39.90
inkl. MwSt. zzgl. Versand
Versand: €0.00

Prom-In CFM Pure Performance 2250 g strawberry / Whey Protein / Instant-Whey Protein Konzentrat CFM, angereichert mit Verdauungsenzymen und Probiotika
€100.16
inkl. MwSt. zzgl. Versand
Versand: €0.00

MOLIV Gesichtscreme mit lebenden Probiotika. Nährstoffreich 30ml
€39.00
inkl. MwSt. zzgl. Versand
Versand: €0.00

MOVit Probiotika – Komplex von Laktobazillen und Bifidobakterien, 90 vegetarische Kapseln
€26.49
inkl. MwSt. zzgl. Versand
Versand: €0.00

SYMBIOFLOR 1 Probiotika für die Bronchien und Atemwege 2X50 ml
€36.52(€365.20 / l)
inkl. MwSt. zzgl. Versand
Versand: €0.00

Probiotika Probiotische Essenz 500 ml 11 öko
€43.99
inkl. MwSt. zzgl. Versand
Versand: €6.99

Prom-In CFM Pure Performance 1000 g pistachio / Whey Protein / Instant-Whey Protein Konzentrat CFM, angereichert mit Verdauungsenzymen und Probiotika
€56.75
inkl. MwSt. zzgl. Versand
Versand: €9.99

Dr. Ohhira Probiotika OM-X – 12 Bakterienstämme + Präbiotika & Postbiotika – 3 Jahre fermentierter Pflanzenextrakt – Darmflora – 30 Kapseln
€32.00
inkl. MwSt. zzgl. Versand
Versand: €0.00

SANA-PRO Probiotika immun / 180 g
€81.90(€455.00 / kg)
inkl. MwSt. zzgl. Versand
Versand: €0.00

Darmpulver für Hunde 3x200g - bei Darmproblemen von Balloony | Probiotika Hund, Für Verdauung & Darmpflege, stabile Darmflora
€119.97(€199.95 / g)
inkl. MwSt. zzgl. Versand

SANTE Skin Protection Toner Probiotika 125 ml
€6.99(€55.92 / l)
inkl. MwSt. zzgl. Versand
Versand: €4.99

Die Rolle von Probiotika in der Zahnmedizin, Taschenbuch von Priyanka Srivastav , Anamika Sharma , Nitin Tomar, Verlag Unser Wissen, 9786209246401
€54.90
inkl. MwSt. zzgl. Versand
Versand: €0.00

Formulierung von 'Saint-Paulin'-Käse mit Probiotika, Taschenbuch von Imen Mahmoudi, Verlag Unser Wissen, 9786203986013
€54.90
inkl. MwSt. zzgl. Versand
Versand: €0.00

Biorepair Zahnpasta Peribioma - 3er Pack (3×75 ml) – Zahnfleischschutz, Probiotika & Pflege für empfindliche Zähne
€19.90
inkl. MwSt. zzgl. Versand
Versand: €0.00

Reflex Nutrition Supergreens & Gut Support (90 Caps) Unflavoured - Vitamine, Mineralien & Gesundheit - Probiotika
€18.27
inkl. MwSt. zzgl. Versand
Versand: €0.00

BioTabs Startrex 5kg Bodenverbesserer mit Probiotika | Organischer Dünger für gesunde Pflanzen in Erde und Kokos
€59.90(€11,980.00 / kg)
inkl. MwSt. zzgl. Versand
Versand: €5.90

SANA-PRO Probiotika immun / 60 g
€34.90(€581.67 / kg)
inkl. MwSt. zzgl. Versand
Versand: €0.00

SANTE Skin Protection Nachtcreme Probiotika 50 ml
€16.95(€339.00 / l)
inkl. MwSt. zzgl. Versand
Versand: €4.99

Nachtcreme mit Probiotika und Präbiotika SYNBIOTIC HOME CARE Apis 50 ml
€11.99
inkl. MwSt. zzgl. Versand
Versand: €4.95

Probiotika: Ein wirksamer Beschleuniger für die Kalziumabsorption, Taschenbuch von Mehul Bagde , Dipansu Sahu , Lalit Chaudhary, Verlag Unser Wissen,
€43.90
inkl. MwSt. zzgl. Versand
Versand: €0.00

SANTE Sensitive Care Shampoo - Probiotika 950ml
€14.99(€15.78 / l)
inkl. MwSt. zzgl. Versand

Die schützende Wirkung von Probiotika, Taschenbuch von Juan Luis Santos, Verlag Unser Wissen, 9786208809270
€43.90
inkl. MwSt. zzgl. Versand
Versand: €0.00

Probiotika und Mundgesundheit, Taschenbuch von Ananthalekshmy Rajeev , Basavaraj Patthi , Ashish Singla, Verlag Unser Wissen, 9786204349756
€39.90
inkl. MwSt. zzgl. Versand
Versand: €0.00

Isolierung und Identifizierung von Probiotika auf Garnelen, Taschenbuch von Razack Rafi Mohamed , Narasimman Manickam , Ambrose Paulraj, Verlag Unser
€65.90
inkl. MwSt. zzgl. Versand
Versand: €0.00

Probiotika und Zahnkaries
€35.90
inkl. MwSt. zzgl. Versand
Versand: €0.00

Omniflora N – Probiotika Kapseln für die Darmflora 100 St
€69.94(€699.40 / ct)
inkl. MwSt. zzgl. Versand
Versand: €0.00

PURE NATURAL CHOICE | NATURAL FLORA KOMPLEX: Hochwirksame Probiotika mit 23 Bakterienstämmen und DARM Balance+ - 180 vegane Kapseln, Hergestellt ...
€29.99
inkl. MwSt. zzgl. Versand
Versand: €0.00

BIOGAIA PROTECTIS BABY Tropfen Probiotic Probiotisch 5ML x 2 kunst Probiotika für Säugling
€35.96
inkl. MwSt. zzgl. Versand
Versand: €0.00

Probiotika in der Parodontalgesundheit und -erkrankung, Taschenbuch von Deepti Mittal , Babitha Gunjiganur Ajjappa , Shobha Prakash, Verlag Unser
€61.90
inkl. MwSt. zzgl. Versand
Versand: €0.00

Ergänzung von Probiotika (ProtexinTM), Taschenbuch von S. Saadullah, Verlag Unser Wissen, 9786203376678
€49.00
inkl. MwSt. zzgl. Versand
Versand: €0.00

SANPROBI STRESS 20 KAPSELN Probiotika
€18.98
inkl. MwSt. zzgl. Versand
Versand: €6.99

Schwangerschaft (Probiotika in der Schwangerschaft) 30 Kapseln
€33.78
inkl. MwSt. zzgl. Versand
Versand: €0.00

Probiotika, Taschenbuch von Manali Rathod , Hiral Parikh , Shilpa Duseja, Verlag Unser Wissen, 9786206228363
€79.90
inkl. MwSt. zzgl. Versand
Versand: €0.00

NUPURE probaflor plus Probiotika Darmgesundh.Kps 60 St
€36.90(€615.00 / ct)
inkl. MwSt. zzgl. Versand
Versand: €0.00

MOVit Probiotika FORTE, 90 Kapseln
€27.99
inkl. MwSt. zzgl. Versand
Versand: €0.00

Entwicklung artenspezifischer Probiotika für Masthühner, Taschenbuch von S. Gunasekaran , R. Karunakaran, Verlag Unser Wissen, 9786206852766
€49.90
inkl. MwSt. zzgl. Versand
Versand: €0.00

Synergistische und antagonistische Wirkungen auf Probiotika (Buch)
€68.90
inkl. MwSt. zzgl. Versand
Versand: €0.00

Prom-In CFM Pure Performance 1000 g strawberry / Whey Protein / Instant-Whey Protein Konzentrat CFM, angereichert mit Verdauungsenzymen und Probiotika
€56.75
inkl. MwSt. zzgl. Versand
Versand: €9.99

Für Frauen (Probiotika für Frauen) 14 Kapseln
€21.79
inkl. MwSt. zzgl. Versand
Versand: €0.00

Probiotika zur Therapie des Reizdarmsyndroms von Erwachsenen
€24.99
inkl. MwSt. zzgl. Versand
Versand: €0.00

Pedigree Hundesnacks Multivitamins Verdauung - 30 weiche Hundeleckerlis mit Probiotika, 180g - Supplements zur Unterstützung der Verdauung, einfac...
€13.49
inkl. MwSt. zzgl. Versand
Versand: €0.00

SYMBIOFLOR 2 Probiotika bei Reizdarm 2X50 ml
€36.52(€365.20 / l)
inkl. MwSt. zzgl. Versand
Versand: €0.00

Bonimed Bactiobon Complex 20 Kapseln Probiotika
€14.99
inkl. MwSt. zzgl. Versand
Versand: €6.99

MedibiotiX Mental | Komplex für Nerven & Psyche | B-Vitamine, Prä- und Probiotika, Pflanzenextrakte, 30 Sachets | Bessere Konzentration | Anti-Stress
€38.95(€386.41 / kg)
inkl. MwSt. zzgl. Versand

Probielle Balance Probiotika 30 St
€27.80(€926.67 / ct)
inkl. MwSt. zzgl. Versand
Versand: €0.00

Immunostimulanzien, Probiotika und Präbiotika, Taschenbuch von Subha Ganguly, Verlag Unser Wissen, 9786203125009
€49.00
inkl. MwSt. zzgl. Versand
Versand: €0.00

Beauty of Joseon Reis & Probiotika Sonnencreme SPF50+ PA++++
€26.50
inkl. MwSt. zzgl. Versand
Versand: €0.00

Das Good Gut Diet Kochbuch: Mit Präbiotika und Probiotika
€18.33
inkl. MwSt. zzgl. Versand
Versand: €0.00

Probiotika in der Parodontalgesundheit und -erkrankung
€61.90
inkl. MwSt. zzgl. Versand
Versand: €4.90

MOVit Probiotika FEMINA EXTRA STRONG, 90 Kapseln
€29.99
inkl. MwSt. zzgl. Versand
Versand: €0.00

Garnier Body Intensive 7 Days Pflegende Körperlotion mit Sheabutter + Probiotika (400 ml)
€5.70
inkl. MwSt. zzgl. Versand
Versand: €5.73

Probielle Immun Probiotika zur Unterstützung d. Immunsystems 30 St
€30.00(€1,000.00 / ct)
inkl. MwSt. zzgl. Versand
Versand: €0.00

MOVit Probiotika EXTRA STRONG, 90 vegane Kapseln
€28.99
inkl. MwSt. zzgl. Versand
Versand: €0.00
Auswirkungen der Gefriertrocknung auf mikroverkapselte Probiotika, Taschenbuch von María Alejandra Asensio Ruiz , María Encarnación Morales Hernández
€59.90
inkl. MwSt. zzgl. Versand
Versand: €0.00

Ambling Pflanzen-Probiotika Balance Ampulle
€30.00
inkl. MwSt. zzgl. Versand
Versand: €5.00

Digestiv Enzymes+ (120 Kapseln) Nahrungsergänzungsmittel, Präbiotika, Probiotika, Verdauung, Darmgesundheit, Verdauungsenzyme, Blähungen
€49.99
inkl. MwSt. zzgl. Versand
Versand: €0.00

Aavalabs Probiotika für Frauen | Darm- & Vaginalflora | 45 Milliarden KBE
€23.99
inkl. MwSt. zzgl. Versand
Versand: €0.99

Hyaluronserum bio 1,2% mit Probiotika | ruhi | 4 Hyaluronarten & Antioxidantien | Anti-Aging Naturkosmetik gegen Falten | Bio, vegan & Made in Germany
€79.00(€2,633.33 / l)
inkl. MwSt. zzgl. Versand
Versand: €0.00

Raab Vitalfood Multi Vitamin Plus | 60 Kapseln | 13 Vitamine & 7 Mineralstoffe | OPC, Curcumin & Probiotika | vegan
€18.90
inkl. MwSt. zzgl. Versand
Versand: €4.90

MOLIV TRY ME BOX | Probiotisches Hautpflege Kennenlern-Set | Gesichtspflege mit lebenden Probiotika zum Testen (Serum, Creme, Oleo-Gel)
€28.00
inkl. MwSt. zzgl. Versand
Versand: €0.00

Synergistische und antagonistische Wirkungen auf Probiotika, Taschenbuch von Neha Jangbari , Archana Rana , Usmangani Tabani, Verlag Unser Wissen,
€68.90
inkl. MwSt. zzgl. Versand
Versand: €0.00
